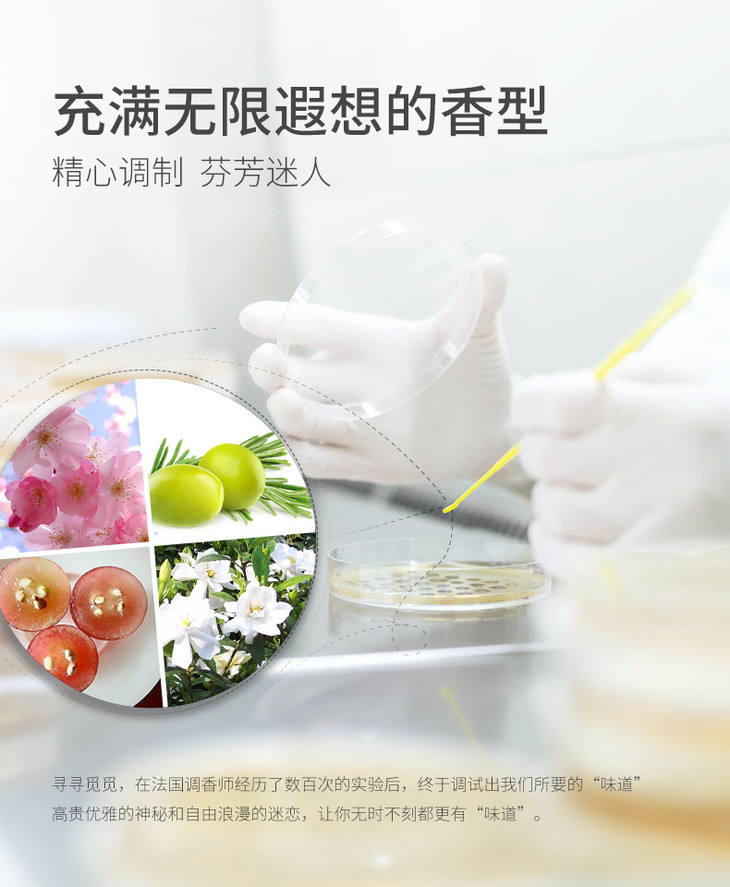

【初夏堂】真爱身体乳保湿滋润补水修护鸡皮
¥69.90
-
初夏堂护肤旗舰店
(微信公众号认证)
- 萃取天然植物精华,专注于天然护肤,为你成就更美丽,更自信的自己。天然臻萃,之美如初。是我们所以一直坚持的新年。
- 扫描二维码,访问我们的微信店铺
- 随时随地的购物、客服咨询、查询订单和物流...
【初夏堂】真爱身体乳保湿滋润补水修护鸡皮
1. 打开微信,扫一扫左侧二维码
2. 点击右上角图标

3. 发送给朋友、分享到朋友圈、收藏

打开微信,扫一扫
或搜索微信号:chuxiatang
1. 打开微信,扫一扫左侧二维码
2. 点击右上角图标

3. 发送给朋友、分享到朋友圈、收藏